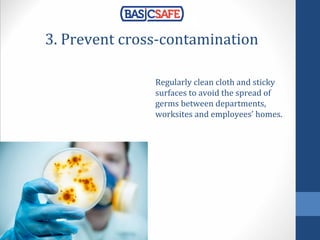
3. Prevent cross-contamination
Regularly clean cloth and sticky
surfaces to avoid the spread of
germs between departments,
worksites and employees’ homes.

The document provides 10 effective tips for workplace housekeeping to enhance safety and efficiency, highlighting the importance of cleanliness in reducing hazards. Key recommendations include preventing slips and falls, controlling fire hazards, training employees, recognizing safe behavior, and maintaining organized storage. It emphasizes the role of good housekeeping as an indicator of management quality and employee engagement.